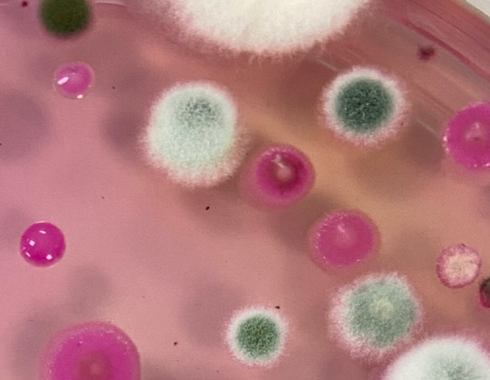
Close up of mould under a microscope

Our Laboratories
Each of our UK offices is equipped with scientific tools to assess the physical and mechanical properties of materials. We also offer techniques to identify material composition and detect contamination. These facilities support forensic investigations, insurance claims, and engineering assessments across a wide range of materials, including metals, glass, fibres, wood, polymers, and rubber.

MICROSCOPY
Microscopes are essential in any lab. Ours offer magnification up to 6000x, allowing us to examine defects, cracks, and grain structures in detail. We can also produce 3D maps and depth profiles.

SAMPLE PREPARATION
Preparing samples is key in metallurgy. It helps reveal grain structures and allows for further testing, such as hardness and elemental analysis.

X-RAY FLUOROSCOPY
XRF provides quantitative elemental analysis in both lab and field settings. It’s useful for investigating contamination, metal composition, and more.

HARDNESS TESTING
Understanding hardness helps explain how and why materials fail. We test metals, polymers, glass, and rubber using both lab-based and portable equipment.

CHEMICAL TESTING
Chemical tests help us detect bacteria in pipework, assess metal cracking risks, and check polymer compatibility with chemicals. Our labs are stocked with the necessary reagents and equipment.
MOULD IDENTIFICATION
Mould can affect health and property and cargo. We identify moulds and can use them to help date events such as water damage.
OUR EQUIPMENT
Our labs use a wide range of tools to support high-quality forensic investigations, including:
- X-rays for examining components before disassembly.
- Scanning Electron Microscopy (SEM) for surface analysis.
- Energy Dispersive X-ray Spectroscopy (EDX) for elemental composition.
- Fourier Transform Infrared Spectroscopy (FTIR) for chemical bonding analysis.
- Ion Chromatography for liquid chemistry testing.
- X-ray Diffraction for crystalline structure analysis and material composition.
- Inductively Coupled Plasma Optical Emission Spectroscopy (ICP-OES) for detailed elemental analysis.
- Surface roughness and friction measurement tools.
- Drone and laser scanning for scene documentation.
These capabilities allow us to deliver clear, evidence-based insights to insurers, legal professionals, and industry clients, supporting dispute resolution, understanding failures, and preventing future incidents.





